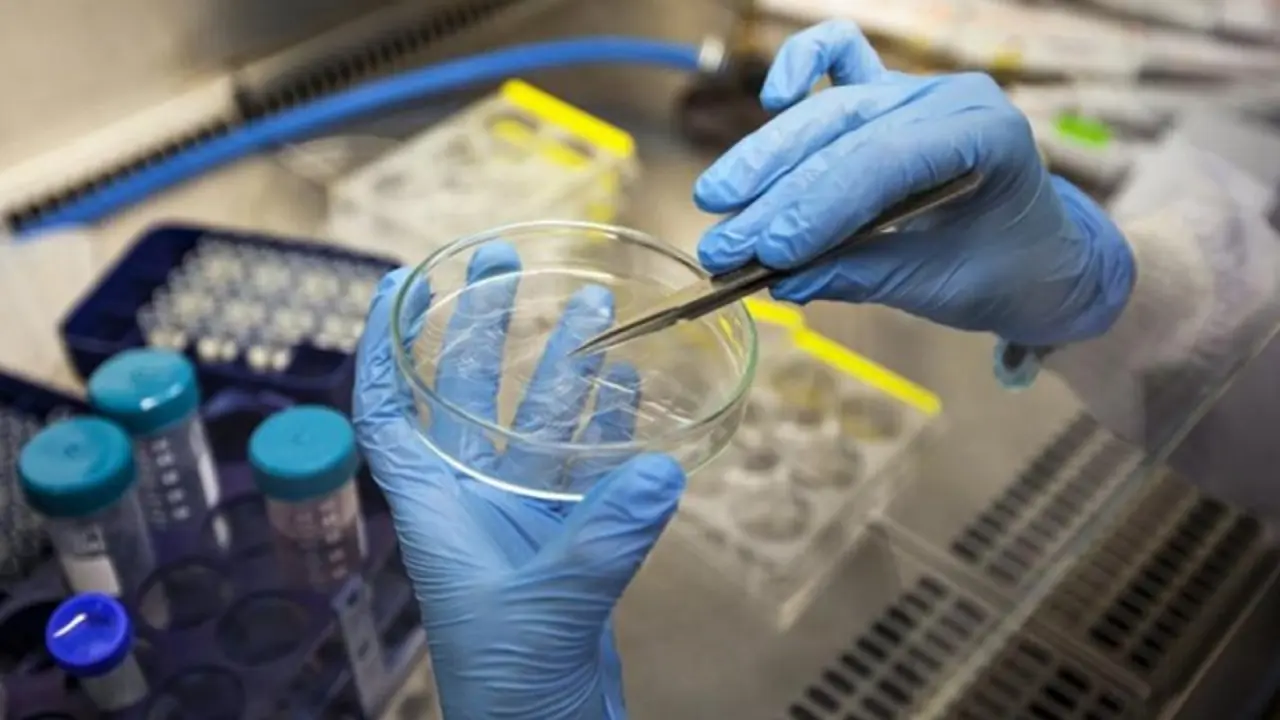

La AECC habilita 85 'espacios sin humo' en Arroyo de la Encomienda junto a zonas de salud, parques e instalaciones deportivas
El Ayuntamiento de Arroyo de la Encomienda y la Asociación Española contra el Cáncer en Valladolid firmaron este miércoles el convenio para la…
07/03/24 | 8:15